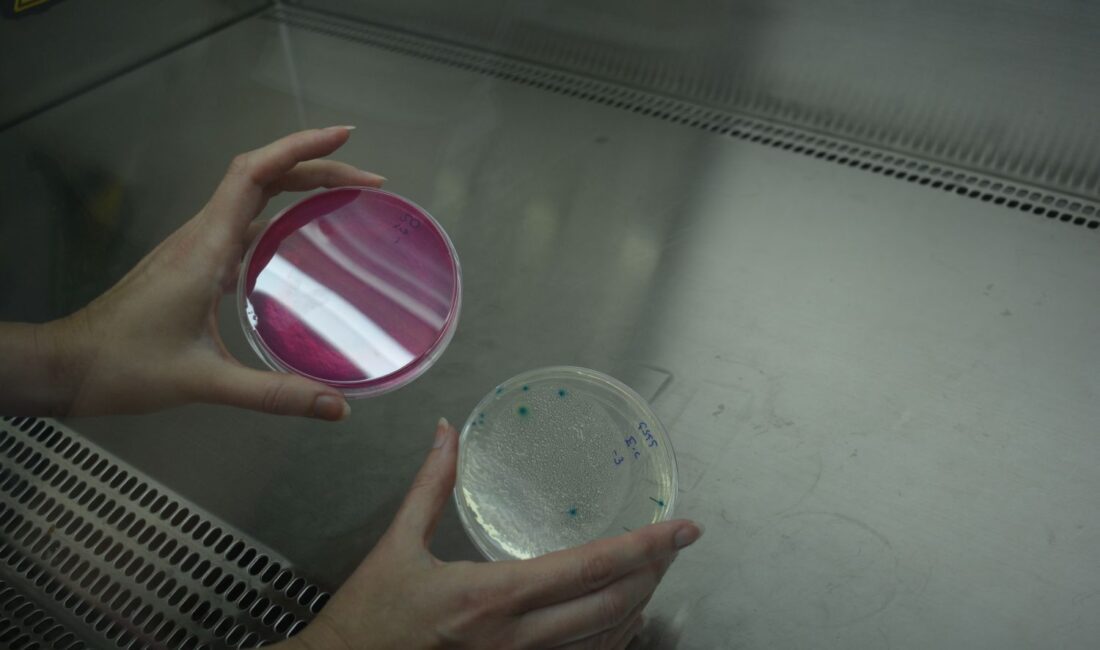
EGEMİKAL mikrobiyolojik analizlerde akreditasyon güvencesi sağlıyor Ege Üniversitesi Mikrobiyolojik Analiz Laboratuvarı EGEMİKAL dezenfektanlarından su analizlerine kadar

İZMİR (Ege Ajans) Ege Üniversitesi Çevre Sağlığı ve Biyosidal Analiz Laboratuvarı (EGEMİKAL), biyosidal ürünlerin analizinde Türkiye’nin öncü laboratuvarı olarak, uzman ekibiyle hastane dezenfektanlarından su analizlerine kadar geniş bir yelpazede titiz ve güvenilir akredite testler gerçekleştiriyor.

EGEMİKAL Devlet bünyesinde güvenilir analizler yapıyor
EGEMİKAL Analiz Laboratuvarının akreditasyon süreci üzerine konuşan Laboratuvar Müdürü Prof. Dr. Güven Özdemir, “Akreditasyon sürecinde, denetlenebilir akreditasyon mantığında iş yapan laboratuvarlar öne çıkmaya başlamıştı. Dolayısıyla bizim bölüm içerisinde yaptığımız analizlerin artık yakın bir zamanda geçerliliği olmayacaktı. O yüzden yetkilendirme önemliydi, bunu da bir çatı altında toplamak için böyle bir laboratuvar oluşumuna ihtiyaç vardı. Devlet bünyesinde yer alan güvenilir laboratuvar sayısı çok az. Var olanlar da maalesef sürdürülebilirlik anlamında kendilerini devam ettiremedikleri için kapanma yoluna gitti. Akreditasyon kriterleri ağırlaşınca yetkili laboratuvar sayısı da azalmaya başladı. Sonuç olarak, dezenfektan analizleri alanında devlet üniversiteleri arasında yetkili olarak biz yer alıyoruz” dedi.
Prof. Dr. Özdemir, laboratuvarda çalışan ekibin uzmanlığına da dikkat çekerek şöyle devam etti. “Burada çalışan tüm arkadaşlarımız belli alanlarda lisansını tamamlamış, doktorasını yapmış ve doktorasını yaptıktan sonra da bu alanda uzmanlaşmak için belli standart yöntemleri uygular hale gelmiş bireylerden oluşuyor. İçimizde toksikoloji testlerini yapan, irritasyon testlerini gerçekleştiren, mikrobiyolojik ve kimyasal analizleri yürüten birçok uzman arkadaşımız var.
Hepsi farklı uzmanlık alanlarından gelen, birikimli kişiler. Laboratuvarımız COVID döneminde Bakanlık ile birlikte çalışarak bu dönemdeki birçok yönetmelik ve yönergenin oluşturulmasına katkı sağladı. Çünkü o dönem bir karışıklık vardı; birçok cihazın ve ürünün mevzuata bağlanması gerekiyordu. Ayrıca eğitim kuruluşları ve sanayi sektörüyle Ar-Ge ve Ür-Ge çalışmalarımız sürüyor. Bazı ürünlerin geliştirilmesinde önemli roller üstleniyoruz. Üniversitelerin araştırma projeleri ve TÜBİTAK ile yürütülen projeler de hizmet alımı şeklinde gerçekleştiriliyor. Standartlar sürekli revize ediliyor ve biz de bu standartlara uyum sağlamak için kendimizi sürekli güncelliyoruz.”

“Biyosidal Ürünlerde Türkiye’nin En Kapsamlı Laboratuvarı”
EGEMİKAL Analiz Laboratuvarının Türkiye’de biyosidal ürünlerin analizinde öncü konumda bulunduğunu belirten Kalite Yönetim Sorumlusu Dr. Öğr. Üyesi Aslı Şahiner Danışkan, “Mikrobiyoloji alanında en fazla akredite biyosidal ürün analiz yöntemine sahibiz. Biyosidal ürünler; dezenfektanların tamamı, içme ve havuz sularının dezenfeksiyonu amacıyla kullanılan kimyasalların analizlerini kapsıyor. Kimyasal ve fiziksel analizler, mikrobiyolojik etkinlik testleri, stabilite çalışmaları, irritasyon testleri gibi birçok analiz laboratuvarımızda gerçekleştirilebiliyor. Ayrıca kozmetik analizleri, içme ve kullanma sularının mikrobiyolojik analizleri, plastik, tekstil gibi antimikrobiyal malzemelerin testlerini de burada yapabiliyoruz. Türkiye çapında antimikrobiyal testler bakımından en kapsamlı analizleri yapan laboratuvar şu anda EGEMİKAL’dır.” diye konuştu.
Dr. Şahiner Danışkan, analiz sürecinin her aşamasının titizlikle kayıt altına alındığını belirterek şöyleyerek “Numunenin laboratuvara giriş sürecinden raporun müşteriye teslim edildiği ana kadar olan tüm süreç kayıt altına alınıyor. Geriye dönük izlenebilirlik açısından her şey kayıt altında. Laboratuvarın sıcaklığı ve cihazların günlük kontrolleri sağlanıyor. Analizi yapan arkadaşlarımız tüm ham verileri kayıt altına alıyor. Bu süreç tamamen izlenebilir. Buraya özgü geliştirdiğimiz ‘eldis’ isimli yazılım sistemimiz sayesinde bir numune kod ile kayıt altına alınıyor ve bu kod üzerinden tüm süreç takip edilebiliyor. Hangi cihazla, hangi gün ve saatte, hangi standartla analiz yapıldığı gibi tüm bilgilere erişim sağlanabiliyor.” dedi.

“Gizlilik ve kalite kontrol, güvenirliğin temeli”
Personelin, akreditasyonun bir gerekliliği olarak müşteri gizliliği ve tarafsızlık sözleşmesi imzaladığını söyleyen Dr. Şahiner Danışkan, “Laboratuvar müdürü de çalışanlarına baskı uygulamayacağına dair beyanda bulunuyor. Sisteme herkes kendi şifresiyle giriş yapıyor; böylece sorumlu oldukları alanlar net şekilde belirleniyor. Uluslararası metotlarla çalışıyoruz. Her yıl yeterlilik ve karşılaştırma testlerine katılıyoruz. Aynı numune birçok laboratuvara gönderiliyor ve z-skor ile yeterlilik kontrolü yapılıyor. Dış kalite kontrolün yanı sıra iç kalite kontrol çalışmalarımız da var. Aylık, üç aylık ya da analiz tipine göre değişen periyotlarla kalite kontrol sağlıyoruz. Hangi hastane olursa olsun, satın aldığı dezenfektanların güvenilirliğini ve işlevselliğini bizim laboratuvarımıza denetlettirebilir. Gençlik ve Spor Bakanlığı gibi kamu kurumlarının analiz taleplerini de karşılıyoruz.” diye konuştu.
“Dezenfektanlar hasta sağlığı açısından kritik öneme sahip”
Dezenfektanların iyi analiz edilmesi gerektiğini vurgulayan Dr. Meryem Koruyucu ise “Hastane dezenfektanlarının etkinliği ve uygunluğu, sağlık güvenliği açısından uzman laboratuvarlarca titizlikle denetlenmelidir. Laboratuvarımız, hastanelerde kullanılan dezenfektanların etkinliğini ve uygunluğunu denetleyen önemli bir merkez olarak faaliyet göstermektedir. Dezenfektanlar, hastane hijyeni ve hasta sağlığı açısından kritik bir rol oynar. Örneğin, endoskopide kullanılan aletlerin dezenfeksiyonunda kullanılan kimyasalların aktif madde konsantrasyonu çok önemlidir. Bu malzemelerin antiseptik hale geldiğinden emin olmak için dezenfektanlardaki etken madde miktarları mutlaka yetkin laboratuvarlarca analiz edilmelidir.” dedi.